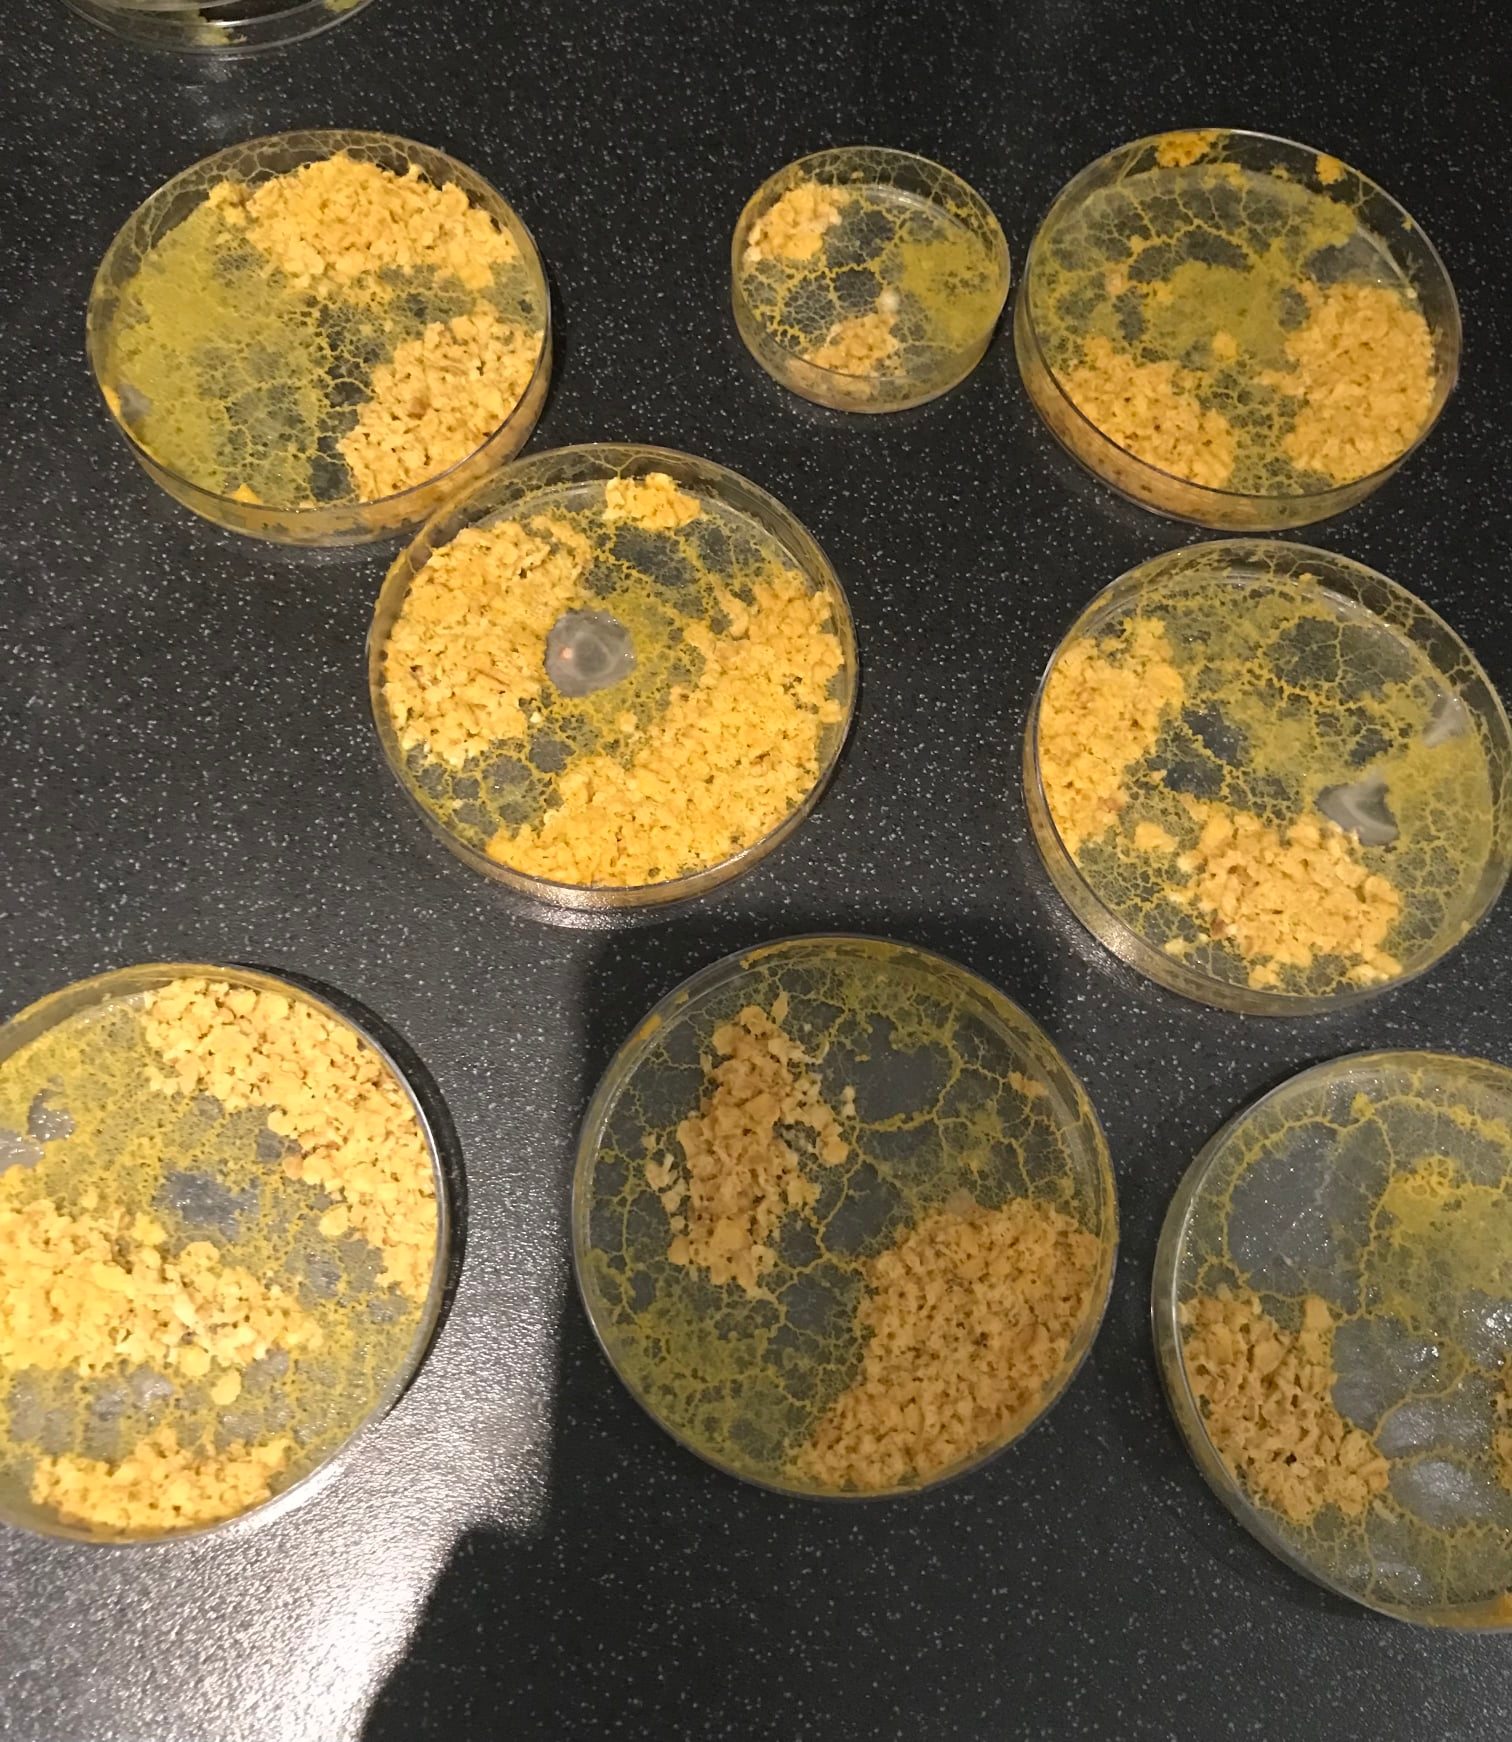

BELLES FÊTES DE FIN D’ANNÉE A TOUS !

ILLUMINATIONS ET CÉLÉBRATION DE NOËL




NOS PORTES OUVERTES







TRAVAIL DE MÉMOIRE DE NOS ÉLEVÉS DE 3E


PORTES OUVERTES 2025
LES INSCRIPTIONS POUR L’ANNÉE 2026-2027 SONT OUVERTES. VENEZ VISITER NOTRE ÉTABLISSEMENT LE VENDREDI 21 NOVEMBRE 2025 DE 17H A 19H

VOYAGE A BERLIN OCTOBRE 2025
Nos élèves de 4e et de 3e ont pris la route pour Berlin ! Une semaine riche en découvertes.





VOYAGE EN BRETAGNE OCTOBRE 2025
Nos élèves de CE2, CM1, CM1/CM2 et CM2 ont eu l’occasion de partir une semaine en Bretagne. De belles découvertes, pêche, dunes, tournage d’un film, travail d’équipe.






CROSS 2025
Pour la première fois, le CROSS s’adressait aux élèves de la TPS à la 3e. C’était l’occasion pour les plus grands de soutenir et d’aider les plus jeunes. Un beau moment de partage !






CÉLÉBRATION DE RENTRÉE
Le 18 septembre 2025, nous avons célébré cette nouvelle année.
Bénédiction des cartables, chants d’année, soleil et compassion étaient au rendez vous.




RENTRÉE 2025
Rentrée en grande pompe à Saint Georges !





BONNES VACANCES !
Toute l’équipe vous souhaite de belles vacances d’été !
L’établissement ferme ses portes
vendredi 11 juillet à 17h30 et réouvre le 21 aôut à 8h30.

LISTES DES FOURNITURES SCOLAIRES 2025-2026
















PORTES OUVERTES : 08 MARS 2025 DE 10H A 13H
Les inscriptions sont actuellement ouvertes : vous pouvez nous contacter au 02.32.45.20.79 de 7h50 à 18h30


ENVOYER UNE CARTE DE VŒUX
Nos élèves de CM1-CM2 ont rédigé et mis en page une carte de vœux adressée à un proche. Les élèves se sont rendus à la poste de Beaumont le Roger pour y envoyer leur lettre. Une chouette expérience !



DNB BLANC
Les 9 et 10 janvier 2025, l’Ambiance était studieuse pour nos élèves de 3èmes. Un premier brevet blanc qui leur permet de s’immerger dans les conditions réelles d’examen.


BONNE ANNÉE 2025 !!!
L’équipe éducative et pédagogique vous souhaite une très belle année 2025. Que celle-ci vous apporte joie bonheur et réussite.


CÉLÉBRATION DE NOËL ET DÉFIS
Un bravo à tous pour votre participation à tous ces défis du mois de décembre !
Merci à tous pour votre aide afin de vivre comme chaque année une journée de célébration de Noël digne de ce nom.








INFO URGENTE : Dès septembre 2026, le diplôme du brevet des collèges sera obligatoire pour passer en seconde. Nous accueillerons en priorité les élèves qui auront passé plusieurs années à saint Georges afin de ne pas surcharger les classes de 3ème et garder ainsi les bonnes conditions d’apprentissage pour obtenir leur diplôme.







PARTICIPATION AU TELETHON
Tout l’établissement s’est mobilisé pour participer au TELETHON.
Cette année, le thème était « tous bâtisseurs » et nous devions récolter le plus de boites de conserves possibles qui ont été vendues au profit du TELETHON.
Merc à toutes nos familles qui ont participé à ce défi !





VOICI LES DIFFERENTES MANIFESTATIONS ORGANISEES PAR L’APEL :



RÉSULTATS DNB/CFG 2024
UN GRAND BRAVO A TOUS NOS ÉLÈVES !!!

Taux de réussite au DNB 2024 : 94%
Admis mention Très bien : 25%
Admis mention bien : 27%
Admis mention assez bien : 21%
Admis sans mention : 21%
Taux de réussite au CFG 2024 : 100%


RENTRÉE DU 02 SEPTEMBRE 2024
8h30 à 9h : Rentrée des maternelles (les toutes petites section TPS, feront leur rentrée le 03 septembre à 8h20)
9h : Rentrée des primaires
8h30 : Rentrée des 6e
13h20 : Rentrée des 5e 4e 3e

BONNES VACANCES !!!
L’établissement ferme ses portes le 12 juillet 2024 et rouvrira le 22 aout 2024.


LISTES DE FOURNITURES 2024-2025
Attention : pour la classe de CE1-CE2, se référer aux listes CE1 et CE2.















CLAP DE FIN POUR TOUS NOS ÉLÈVES
Ce fut encore une année riche à Saint Georges ! Un grand merci tous.











CNRD 2024
Les élèves de 3e et leur professeur madame Guivarch sont très fiers d’avoir reçu le prix départemental académique pour leurs travaux pour le concours national de la Résistance et de la Déportation. Un grand BRAVO !





TRAVAUX DES ELEVES DE MATHEMATIQUES DE 4EME





Objectif 6ème du 19 février 2024








Nos portes ouvertes du 17 février 2024











16 février 2024 : Devoir de mémoire – Témoignage de Jean Paul Jouachim





12 et 13 février 2024 : Futuroscope pour les élèves de 6e et de 4e !












12 février 2024 : En prévision de la cérémonie des Cendres, Père Audace nous a réunis pour bruler le buis.











Notre manoir sous la neige…






CELEBRATION DE NOËL





TELETHON 2023

MERCI A TOUS !!!

CULTURE CHRÉTIENNE
Ce mardi 14 novembre nos élèves de 6e sont allés visiter l’église de Beaumont le Roger en compagnie de Madame Thabourin, du Père Audace et de Sœur Marie- ELa. Ce fut l’occasion de découvrir les noms des différents Saints.


JOURNÉE CONTRE LE HARCÈLEMENT
Jeudi 09 novembre nos élèves de primaires ont « travaillé » à lutter contre le harcèlement. Une belle journée de réflexion et de partage.


PORTES OUVERTES
VENDREDI 24 NOVEMBRE 2023 DE 17H A 19H
Les inscriptions sont déjà ouvertes dans notre établissement ! Venez nous rencontrer et découvrir Saint Georges !


RÉUNION D ‘INFORMATIONS CM2
Vous souhaitez inscrire votre enfant en 6ème pour la rentrée prochaine ?
Vous pouvez contacter l’établissement dès maintenant ! Nous vous donnons rendez vous le 10 novembre 2023 pour une réunion d’informations le 10 novembre 2023 à 18h.


GAZETTE DES MATHEMATIQUES SEPTEMBRE/OCTOBRE 2023
Cette année nos 4èmes vont réaliser une gazette des Mathématiques hebdomadaire en accord avec leur projet pédagogique Arts et Médias. Les journalistes en herbe vont nous faire découvrir la vie des mathématiciens et des mathématiciennes célèbres, la signification de certains nombres (par exemple, nombre Pi, nombre d’or…). Le premier numéro de la gazette est déjà sorti et affiché dans la classe des 4èmes « Hugo » et dans le couloir du collège pour tous les curieux et désireux d’apprendre. A suivre…






JOURNEE D’INTEGRATION DES ELEVES DE 6EME
Cette année, les élèves de 6ème ont pu découvrir les jeux collaboratifs. Chacun pouvait défier un camarade de la pyramide et ce dernier choisissait le jeu. Ce fût une très belle journée pour faire connaissance et lier des amitiés. Un goûter rafraichissant a permis à tous de reprendre des forces avant de rentrer à la maison. Les enfants et les enseignants étaient ravis. BIENVENUS A TOUS DANS LA CLASSE DE 6EME !





Nous vous souhaitons de belles vacances !
L’établissement ferme ses portes du 14 juillet au 23 aout 2023.
Réouverture le 24 aout 2023. Au plaisir de vous revoir !



RÉSULTATS CFG/DNB 2023
CFG : 4 admis, 0 non admis, soit, 100% admis
DNB : 33 admis, 1 non admis soit, 97.05% admis
Mentions:
Très bien : 15.15% soit, 5 élèves
Bien : 39.39% soit, 13 élèves
Assez bien : 21.21% soit, 7 élèves
Sans : 24.24%, soit, 8 élèves

LISTES DE FOURNITURES ÉCOLE 2023-2024











LISTES DE FOURNITURES collège 2023-2024






LE CLASSEMENT DES MEILLEURS COLLÈGES POUR PRÉPARER LE BREVET EN NORMANDIE
Le ministère de l’Éducation nationale vient de publier ses indicateurs de résultats pour l’ensemble des collèges publics et privés sous contrat. Découvrez le résultat de votre établissement.
Dans quels collèges de Normandie les élèves sont-ils le mieux préparés pour le brevet? Le ministère de l’Éducation nationale a publié ce mercredi « les indicateurs de valeur ajoutée » pour l’ensemble des établissements en France.
En comparant les résultats obtenus avec ceux attendus -calculés en prenant en compte différents facteurs, comme l’âge et le sexe des élèves, leur origine sociale et leur niveau à l’entrée du collège-, il est possible d’établir la « valeur ajoutée » de chaque établissement.
L’approche en valeur ajoutée permet de mesurer « l’apport d’un établissement » et « son efficacité propre », en « comparant la réussite de chacun de ses élèves à celle d’élèves comparables scolarisés dans des établissements comparables », résume le service statistique ministériel en charge des statistiques sur l’éducation (DEPP).
Dans notre classement ci-dessous se trouve la liste des cinq collèges qui affichent la plus forte valeur ajoutée en Normandie. Elle est calculée sur la moyenne des notes obtenues à l’écrit (le brevet s’évalue sur un total de 800 points, dont la moitié sur un contrôle continu en 3e et l’autre moitié sur des examens finaux composés d’épreuves de français, de mathématiques, d’histoire-géographie et de sciences, ainsi que d’une épreuve orale).
Dans la région, le collège privé Saint Paul, à Cherbourg-en-Cotentin, apparaît comme le plus performant, avec une note moyenne de 13,9 au brevet, soit 2,9 points de plus que les résultats attendus. Il devance un établissement public -à Montebourg- et trois collèges privés- à Beaumont-le-Roger, Saint-Pierre-en-Auge et Yvetot.
Les 5 collèges de Normandie dont la valeur ajoutée est la plus forte
- Collège privé Saint Paul (Cherbourg-en-Cotentin) – 99% de réussite, 13,9 de moyenne à l’écrit (+2,9)
- Collège Tiphaigne de la Roche (Montebourg) – 93% de réussite, 11,4 de moyenne à l’écrit (+2,5)
- Collège privé Saint George (Beaumont-le-Roger) – 95% de réussite, 11 de moyenne à l’écrit (+2,2)
- Collège privé Sainte-Thérèse (Saint-Pierre-en-Auge) – 98% de réussite, 12,9 de moyenne à l’écrit (+2)
- Collège privé Bobée (Yvetot) – 100% de réussite, 12,1 de moyenne à l’écrit (+2)

NOTRE JOURNEE PORTES OUVERTES
SAMEDI 18 MARS 2023
Un grand MERCI à l’APEL, l’équipe éducative et les membres de l’OGEC pour leur investissement !







CARNAVAL DU JEUDI 16 MARS 2023
Une très belle journée illuminée par un soleil radieux et surtout par les magnifiques costumes de nos élèves










VENEZ NOMBREUX !


JOURNEE A THEME : COIFFURE FARFELUE !




CONCOURS DE CRECHE
Jeudi 9 février 2023, nous avons reçu le 1er prix académique du concours de crèche du monde. Nous avons gagné le 1er prix !





PATINOIRE POUR NOS ÉLÈVES DE CP
Après plusieurs séances de patinage, les élèves de CP progressent ! Lors de leur séance de jeudi 02 février ils ont eu l’occasion d’assister à une partie de l’entrainement d’une équipe américaine venue spécialement pour la french cup.





SALON DE L’ORIENTATION DE ROUEN
Ce vendredi 03 février 2023 nos élèves de 4ème ont pu découvrir un très grand nombre de métiers au travers d’ateliers divers et variés au salon de l’orientation de Rouen. Ils étaient ravis de leurs découvertes.








NE MANQUEZ PAS NOS PORTES OUVERTES !!!


RÉUNION D’INFORMATION CM2
MARDI 07 FÉVRIER 2023 18H


SAINT GEORGES SOUS LA NEIGE !





PORTES OUVERTES SAMEDI 18 MARS 2023 9H A 12H


GALETTE DES ROIS
Ce lundi 9 janvier 2023, la Galette était à l’honneur… Félicitations à nos reines et rois d’un jour !





Brevet Blanc 3èmes
5 et 6 janvier 2023 : Pour commencer cette nouvelle année, nos élèves de 3ème ont eu l’occasion de s’immerger dans des conditions réelles d’examen. Ambiance studieuse !


Saint Georges vous souhaite une belle année 2023 !


CELEBRATION NOEL 2022





Notre belle célébration de Noël a eu lieu vendredi 16 décembre. Nos élèves musiciens nous ont accompagné lors des chants. Ce temps festif a été suivi de la distribution par les parents de l’APEL d’un verre de chocolat chaud et d’une mandarine.

Illuminations de Saint Georges 2022
Chaque année, la magie reste intacte !







NOTRE MINI FORET DE NOEL


LE TELETHON



















LE CLUB THÉÂTRE DES CLASSES DE 4ème et 3ème VOUS SALUE !







REMISE DES DIPLOMES DNB ET CFG
Mardi 15 novembre 2022, nous nous sommes tous retrouvés pour une soirée spéciale. Les anciens élèves de 3ème sont venus chercher leur diplôme. Ils étaient accompagnés de leurs parents et ont eu grand plaisir à retrouver leurs anciens camarades et professeur principal. Bravo à eux pour leur travail !





VOYAGE BARCELONE DU 16 AU 21 OCTOBRE 2022
Nos élèves de 4ème et de 3ème ont eu la chance de se rendre en Espagne cette année. Au programme, visites, découvertes, spécialités culinaires, activités, rencontres…Ils en sont revenus tous ravis !








CROSS DU VENDREDI 14 OCTOBRE 2022
Nos élèves de la classe de CM1 à la classe de 3ème ont participer au CROSS ce vendredi 14 octobre. L’esprit de compétition, le bonne humeur et la convivialité étaient au rendez-vous. Nos élèves ont passé une très bonne journée !








ÉLECTIONS DES DELEGUES DU 07 OCTOBRE 2022
Les élections des délégués collège sont passées ! Chacune des classes du collège a désormais deux délégués et deux suppléants. Des élèves sérieux et investis !






SORTIE A GISACUM AVEC LES ÉLÈVES DE 6ème VENDREDI 23 SEPTEMBRE 2022
Nos élèves de 6ème ont pu passer une belle journée à la découverte des sports antiques sur le site archéologique de Gisacum.






JEUDI 15 SEPTEMBRE 2022
Sous un ciel clément, a eu lieu notre célébration de rentrée. Les cartables des petits et grands ont pu être bénis par le Père Christophe pour commencer cette belle année.







JEUDI 1er SEPTEMBRE 2022
JOURNÉE D’INTÉGRATION 6ème A VÉLO AU CHÂTEAU D’ HARCOURT
Ce jeudi 1er septembre 2022 a eu lieu la rentrée de nos élèves de 6ème !
A cette occasion, nous nous sommes rendus au château d’ Harcourt pour une journée d’intégration.


















LECTURES CONSEIL POUR LES ELEVES DE 5 ET DE 4ème

Notre célébration de fin d’année




Escapade parisienne avec les 3e
Nous clôturons cette année riche de découvertes avec la visite du centre de Paris et la représentation théâtrale d’Antigone de J.Cocteau.
De la Tour Eiffel au quartier du Marais, en passant par le quai d’Orsay, le Pont Alexandre III et le Louvre, nous avons pique-niquer au jardin des Tuileries.
Puis nous avons rejoint le théâtre de l’Espace Marais pour découvrir une célèbre réécriture du mythe d’Antigone.
Une belle journée partagée avec eux!







CREATION DU LUNOSCOPE PAR LES ELEVES DE 6ème ET DE 3ème



LE VOYAGE DES 6ème EN BRETAGNE












Une semaine passée à découvrir la Bretagne, la côte de granit rose, la pêche à pied, les oiseaux, les planètes, Paimpol et l’Ile de Bréhat… Une boum pour finir le séjour et il ne reste plus que des souvenirs… A l’année prochaine pour un autre voyage en 5ème !

ALERTE TECHNOLOGIE !
8 robots « mBot Explorer » ont été livrés au collège et permettront à nos élèves de s’initier à la robotique dans les meilleures conditions. Un grand MERCI à l’APEL St Georges et à l’APEL 27 qui ont rendu possible l’acquisition de ce matériel.








Journée Mémoire







Dans le cadre de leur parcours citoyen, les élèves de 3e ont passé une journée de visites et de découvertes au Mémorial de Caen. L’occasion de réviser pour le brevet et d’apprendre autrement l’Histoire.
Pour clôturer cette journée mémoire, les élèves de 3e sont partis sur les plages du débarquement. Au programme : les batteries allemandes de Longues-sur-mer, le cimetière américain de Colleville et la plage d’Omaha avec son monument aux Braves.
Une belle journée ensoleillée et remplie de découvertes auprès de leurs enseignants Mesdames Guivarch et Granval ainsi que Monsieur Doulé.

FESTIVAL DU LIVRE A DEAUVILLE POUR LES 3ème
Dans le cadre de la valorisation de la lecture, les 3e ont participé au festival livres et musiques de Deauville. Après avoir lu une sélection de quatre ouvrages de jeunesse, les élèves ont voté et se sont retrouvés au CID de Deauville pour la remise des prix. Un bon moment d’échange avec les auteurs, accompagné de concerts musicaux en lien avec les ouvrages. Après un pique nique sur les planches, les élèves sont partis à la découverte de la ville.





Menu 0 déchet créé par les enfants et préparé par le chef et ses aides…







LES CM2 TESTENT LA CLASSE DE SIXIEME
Pendant une demi-journée, les CM2 ont pu se mettre dans la peau des 6ème en testant les cours de français, chimie et d’autres matières. Ils ont beaucoup apprécié ce temps de collégiens…









PORTES OUVERTES 2022
Nos portes ouvertes ont eu lieu le 19 mars 2022. L’occasion pour les enfants et les parents de découvrir toutes les disciplines enseignées, de pratiquer le tir à l’arc, de découvrir la programmation au travers des robots et le théâtre. Très belle journée de rencontre avec les familles !















LA FRISE CHRONOLOGIQUE DES 5ème
En histoire, les élèves de 5ème ont travaillé sur la réalisation de deux cartes mentales géantes sous forme de frises chronologiques.





Le temps s’arrête pour 15′ de lecture (enfants et adultes)
Le temps était comme suspendu, pendant un quart d’heure. Quand tous les élèves lisent en même temps et qu’un grand silence se fait entendre….







LES 6ème et les BLOBS
Les 6èmes ont travaillé les deux premiers trimestres sur les Blobs en S.V.T, ces êtres vivants constitués d’une seule cellule géante! Ils ont imaginé eux même les expériences qu’ils voulaient réaliser (en passant de l’hypothèse à l’imagination du protocole expérimental et bien sûr jusqu’à la réalisation de l’expérience) et ils n’ont pas manqué d’imagination: cantine pour le blob pour savoir ce qu’il préfère manger, expérience pour savoir s’il sait nager, construction d’un labyrinthe pour voir s’il pouvait trouver son chemin jusqu’à sa nourriture, utilisation de colorant alimentaire pour savoir si le blob change de couleur en l’absorbant, des courses de blobs, etc. etc. !

LES 5ème et les couloirs du temps
Les cinquièmes ont remonté les couloirs du temps avec madame Boulier pour arriver au Moyen-âge. Ils sont partis à la découverte de grandes figures telles que Guenièvre ou Lancelot.
Ils ont également apprécié la rencontre avec le poète Chrétien de Troyes.
Son interview vous sera présentée lors de nos portes ouvertes samedi 19 mars prochain. Venez nombreux à sa rencontre.










LES CM2 DECOUVRENT LA SIXIEME





Les élèves de CM2 découvre la physique et la chimie au cours d’expériences au laboratoire.


Puis, c’est au tour de l’art plastique où ils travaillent et découvrent l’art du dessin partagé. Un élève dessine la tête d’un animal et passe son dessin à son camarade. Le camarade doit dessiner alors un corps complètement différent.


SORTIE THEATRE A PARIS ET CITE DES SCIENCES POUR LES ELEVES DE 4EME
Le retour des voyages scolaires au collège Saint Georges. Nos quatrièmes étaient heureux de découvrir les expositions proposées à la cité des sciences et de l’industrie. Ils ont pu tester et explorer différents ateliers (la robotique, l’espace ou meme le gout…). L’après-midi a été toute aussi riche en découverte avec la représentation de Cyrano de Bergerac au théatre du Ranelagh. Une belle première pour un bon nombre d’entre eux pour le plus grand bonheur de leurs accompagnatrices, mesdames Boulier, Clapier, Colnot et Méziat.


ORIENTATION DES 3ème
Dans le cadre de leur #orientation, les élèves de 3e ont rencontré les membres de l’ANEFA #anefa l’association nationale pour l’emploi et la formation en agriculture ; l’occasion pour eux de découvrir plus d’une centaine de métiers en lien avec le domaine agricole.


LES DANGERS DU CYBERHARCELEMENT
Voici le travail des 5ème sur les dangers du net réalisé avec le concours de M Mulet, professeur d’histoire/géographie. Belle réalisation sur le cyberharcèlement !








Temps d’échange pour les 6e Calypso en culture chrétienne
Les élèves avaient la mission de reconstituer les biographies de plusieurs OUVRIERS DE PAIX de par le monde. L’occasion pour eux de partager leurs connaissances et de s’entraider pour relever ce défi. Rendez vous pour la prochaine mission: mimer le personnage choisi et le faire découvrir à ses camarades.


L’ACCOMPAGNEMENT PERSONNALISE
» Séance d’accompagnement personnalisé pour les 4e Alice Milliat encadrée par mesdames Boulier et Colnot. Les élèves sont répartis en fonction de leurs besoins. Quand certains sont en remédiation imparfait/passe simple, d’autres se perfectionnent en orthographe grâce au « projet Voltaire », les derniers finalisent leurs nouvelles fantastiques en vue du concours de nouvelles organisé dans le cadre du 13e festival du livre qui se déroulera à la Saussaye du 7 au 28 mars 2022. »


TRAVAIL DES 6EME BILANGUE
Les 6e bilangue avaient pour consigne d’écrire une lettre aux rois mages pour recevoir des cadeaux (en Espagne ce sont les rois mages et non pas le Père Noël qui apportent les cadeaux). Ils se sont impliqués dans leur travail, Mme Granval est fière d’eux.


LA CULTURE CHRETIENNE
Lors de notre séance de culture chrétienne de janvier, les élèves de 6ème ont pu visiter l’église de Beaumont le Roger où le Père Christophe avait aménagé une crèche de 70m2.








LES ILLUMINATIONS DE NOEL ET LA CELEBRATION (toutes nos vidéos sont sur Youtube : collège Saint Georges Beaumont le Roger)
Vendredi 17 décembre 2021, les membres du bureau de l’APEL, du personnel et les 2 cheffes d’établissement sont venus à 6H30 allumer et déposer quelques 4000 bougies pour le plaisir des enfants. Ce spectacle toujours aussi merveilleux nous a permis de commencer une belle journée ! Le Père Christophe a quant à lui préparé la crèche et la sono pour nous offrir une joyeuse célébration de Noël fort bien réussie. Les enfants ont pu chanter les chants qu’ils avaient révisé tout au long du mois et les élèves de 6ème ont dansé sur un chant de Noël malgache (merci à Soeur Danièle Marie pour ses cours de danse malgache ! ).






























LE TELETHON
Tous les ans, les élèves, les familles et les adultes de la communauté éducative se mobilisent pour recueillir des fonds pour le téléthon. Cette année, nous avons recueilli 458,48 euros grâce à vous! Un grand merci pour cet élan de générosité.

Seconde réunion CVC
Les élèves ont choisi de mener à bien le thème suivant : installer plus de bancs sur la cour. Pour se faire, ils ont besoin de planche, de poutre et de tous les matériaux nécessaires. De plus, ils ont besoin de l’aide de parents, de grands-parents (…) disponibles pour venir aider à les construire. N’hésitez pas à prendre contact avec Mme Thabourin.

Pour l’éducation au développement durable (EDD), les enseignants emmènent les 6e et 5e à la station d’épuration de Beaumont




1ère réunion du CVC (conseil de vie collégienne)
LA VIE DES BLOBS DES 6ème DE SAINT GEORGES SE TROUVE DANS L’ARTICLE CI-DESSOUS :


JOURNEE NICOLAS BARRE, LE PERE FONDATEUR DE NOTRE ECOLE
Journée sans cartable aujourd’hui. Les enfants participent à différents ateliers ce matin et cet après-midi nous nous retrouverons pour célébrer les 400 ans de Nicolas Barré, père fondateur de notre Tutelle.

















REPAS MEXICAIN AU SELF



ESCAPE GAME : Mme Guivarch a proposé à ses élèves latinistes de 3e d’élucider le meurtre de Jules César et de retrouver son héritier à travers un escape game : au programme puzzles autour des œuvres d’art, traduction des présages et code secret pour ouvrir un codex. La tension était à son maximum !





LA JOURNEE CROSS A SAINT GEORGES :
Résultats du cross :
1er – 6ème Calypso
2eme – 4ème Alice Milliat
3ème – Cm2
Bravo à tous les participants et merci aux professeurs d’EPS pour l’organisation, aux professeurs et aux parents volontaires pour l’encadrement.

















LES BLOBS ! EXPERIENCE HORS DU COMMUN EN SVT EN PARALLELE AVEC CELLE DE THOMAS PESQUET A BORD DE LA NAVETTE SPATIALE
Un truc jaune qui n’est ni animal, ni végétal, qui n’a qu’une seule cellule mais qui peut grandir jusqu’à plusieurs mètres et est même capable d’apprendre ! Voilà à quoi ressemble un blob (Physarum polycephalum) !
La candidature du collège a été retenue : en partenariat avec le Centre National de Recherches Scientifiques (CNRS), le Centre National des Etudes Spatiales (CNES) et l’équipage de la Station Spatiale Internationale (ISS), plusieurs classes de 6e vont pouvoir réaliser des expériences sur ces êtres vivants si particuliers dès la rentrée prochaine. Ces expériences seront également menées par Thomas PESQUET à bord de l’ISS, lors de sa mission Alpha de six mois.
Au total, 4500 classes de Primaire, Collège et Lycée vont participer à ce projet de science participative, un des plus grands jamais mené en France.
Ce projet permettra aux élèves de pleinement mettre en œuvre une démarche scientifique et de travailler la communication orale et écrite pour rendre compte des résultats des expériences aux autres élèves du collège mais aussi pour échanger avec les élèves de certaines écoles du secteur qui y participent.
En attendant, voici le lien vers la vidéo de présentation du projet : https://www.youtube.com/watch?v=zqR0jWoYbfw

N’hésitez pas à vous rendre sur la page facebook de l’établissement. Vous y découvrirez en temps réel, les projets réalisés par vos enfants.
Une séance de culture chrétienne avec les 6ème : très belle réalisation des élèves !

EMI / FRANCAIS

Mme Guivarch travaille avec ses élèves de 3e sur les photos de l’AFP de 2021. Ainsi, chacun peut développer ses compétences d’EMI (éducation aux médias et à l’information) et échanger sur les images de presse auxquelles ils sont confrontés. Vous pourrez retrouver le lien de l’activité ici : https://l.facebook.com/l.php?u=https%3A%2F%2Fwww.canva.com%2Fdesign%2FDAErTfR00Hw%2FwOQWQ61XPlipew59yFnfRg%2Fview%3Futm_content%3DDAErTfR00Hw%26utm_campaign%3Ddesignshare%26utm_medium%3Dlink%26utm_source%3Dhomepage_design_menu%26fbclid%3DIwAR11Xj-lh77pup1KsRj4MCTFlSuNbD2HKZ9trWqWGM5SzUk8w09f7JISQRw&h=AT0yCLmiK32lMNHOypuyAUNB-uZacAZRGCm0sZDdMPAfyeC5TdXaYEqCC1gNZkKDVsQaxTgchBHFnNumGgX32C1T2h5-RELgCAuy0Iakqus70y1nGCRJbHtTS-jpP8XrkA&__tn__=-UK-R&c[0]=AT3MmAULewH2sTHYIY5qJXda279ftN1-nR8U0xM5UIdu1K468_M1KQ_nKnZTzAbxDZb5f172q9dkCrao17YAkjHD2pDVbYtrgMH6HEpbXnZNvzbKAKm8n6SzBAckPuHzqQd71UpcrdUE6e80Lt6DH8O933z7D3CmrIPUuJ8D_BVaokTa2rRWruhzr8jZQgEi6GgssZdKmFAxubvPRQ
JOURNEE DE DISTRIBUTION DES CALCULATRICES ET DES LIVRES OFFERTS PAR LE DEPARTEMENT POUR LES CLASSES DE 6ème et de 3ème


CELEBRATION DE RENTREE
Aujourd’hui (17 septembre 2021) avait lieu notre CELEBRATION DE RENTREE et la bénédiction des cartables, blouses et drapeaux de nos élèves. Un beau moment de joie et de partage.
JOURNEE D’INTEGRATION POUR LES 6ème : 1er septembre 2021



LISTE DES FOURNITURES SCOLAIRES 2021/2022
Prévoir l’achat d’une blouse pour le laboratoire

ARCHIVES 2020 2021

CELEBRATION DE FIN D’ANNEE








ESPAGNOL

Les 4èmes bilangues ont travaillé sur les règles d’utilisation des réseaux sociaux en espagnol. Après des recherches sur un site espagnol « Netiquetate » au CDI, chaque groupe a tiré au sort deux règles puis ils ont réalisé des panneaux et présenté les règles à la classe en espagnol.
Chaque année, les classes de collège ont des noms de personnes ou de lieux célèbres choisis par les profs principaux. Cette année il y a eu une 3e Guernica. Les élèves ont donc travaillé sur la ville de Guernica, le bombardement et le célèbre tableau de Picasso. Ils ont fait des recherches au CDI puis chaque groupe a présenté son panneau aux autres en espagnol évidemment. Certains ont pris l’explication du tableau (qu’ils ont préparé en français en arts plastiques et en espagnol) à l’oral du DNB en mai.
CONCOURS BIG CHALLENGE
Voici nos lauréats du Big Challenge. Nos élèves se sont bien classés : Léa Gardez 6eme Athènes est arrivée 2nd du département!
Bravo à tous !
SOUVENIRS DU 1er GROUPE D’ENGLISH +

Malgré la pluie et la crise sanitaire, nous ne pouvions pas quitter nos élèves de 3e sans leur remettre leur tableau d’honneur. C’est avec un pincement au cœur que nous leur souhaitons bonne route vers un avenir plein de réussites !
JOURNEE ROMAINE !
Ce jeudi 17 juin 2021, les élèves latinistes de 3e ont animé entièrement une journée romaine auprès de leurs camarades de 6e. Atelier de boucliers romains, jeu de piste « qui a volé l’éclair de Jupiter? », jeu de plateau pour découvrir les spectacles du Colisée, repas romain, initiation aux sports antiques … les élèves de 3e ont abordé des thèmes vus au cours de leur cursus de latin et ont fait preuve de responsabilités auprès de leurs camarades. Une remise des médailles et un goûter sont venus clôturer cette belle journée.
19 élèves de 3ème, ambassadeurs de leur classe vont se rendre avec leur professeur principal au forum des rencontres de la défense à Bernay. Ils pourront ensuite transmettre les informations recueillies à leurs camarades et les professeurs principaux pourront travailler cet axe d’orientation avec les élèves.
LE CHEMIN DE CROIX AVRIL 2021




LES PETITS DE TPS/PS ONT TRAVAILLE AU TABLEAU DE NICOLAS BARRE. BRAVO POUR CETTE REALISATION !



CETTE SEMAINE, C’EST LA SEMAINE DES MATHEMATIQUES !
Les enseignantes ont préparé des énigmes qui seront affichées dans le collège. Tous les élèves sont concernés et pourront tenter de les résoudre.

LE CARNAVAL
Et voici une partie de nos élèves déguisés pour le carnaval de Saint Georges!




LE DEPARTEMENT DE L’EURE A OFFERT A TOUS NOS ELEVES DE 6ème UN LIVRE :
« Histoires comme ça » de Rudyard Kipling.
C’est le second livre de l’année que le Département de l’Eure offre. Il a également apporté aux élèves de 6ème une calculatrice en septembre.


LE REPAS SAVOYARD A FAIT FUREUR…



LES PORTES OUVERTES DU SAMEDI 6 FEVRIER 2021 DE 9H à 12h sont maintenues en présentiel avec les mesures nécessaires au respect du protocole sanitaire, de l'accueil à la fin de la visite et circuits organisés sans croisement.

L’Epiphanie au self …



CELEBRATION DE NOEL DU VENDREDI 18 DECEMBRE 2021

















TELETHON VENDREDI 4 DECEMBRE 2020
Vendredi 4 décembre 2020, l’établissement a organisé une action en faveur du Téléthon. Afin de respecter le protocole sanitaire, nous avons abandonné l’idée d’une course solidaire et nous avons mis en place un autre projet. A chaque don, une buchette colorée était donnée. Toutes rassemblées, elles ont été collées par des élèves de 3ème sur une plaque de contreplaqué afin de former le mot: ENSEMBLE (thème de l’année). La plaque sera vernie et installée sous le préau.
Il a été récolté la somme de 627,90€.
MERCI A TOUS POUR VOTRE PARTICIPATION !








REFECTION TOTALE DU PORTAIL DE L’ETABLISSEMENT









Démontage total du portail afin de le restaurer et préparation du chantier.

Portail restauré
Séchage et scellement


Le collège, grâce à Mme Méziat et M Mulet, met en place le projet : « éducation au développement durable » dès septembre 2020 pour trois années. La première action commence par la récupération et la logistique du papier récupéré. Puis, à la fin de l’année, une société rémunère le tonnage de papier récupéré. Nous demandons au plus grand nombre possible de familles de garder pour nous leur papier inutile et de nous les déposer aux dates précisées sur le document ci-dessous. D’autres actions suivront tout le long de l’année afin de construire un projet plus complet.
HOMMAGE A L’ENSEIGNANT SAMUEL PATY AU COURS DE LA JOURNEE DU 2 NOVEMBRE 2020. TOUTE LA COMMUNAUTE PROFESSIONNELLE REJOINT SES PROCHES PAR LA PENSEE ET LA PRIERE.
MONUMENT AUX MORTS CREE PAR LES ELEVES DE SAINT GEORGES
Monument aux morts créés par les collégiens de Saint Georges il y a quelques années. Toujours visible proche du monument aux morts de la commune. Les élèves de 3ème vont s’y rendre le vendredi 6 novembre afin de travailler sur le devoir de mémoire et l’étude des symboles. Cette sortie s’inscrit dans le parcours d’enseignement artistique et culturel ainsi que dans le parcours citoyen dans une transdisciplinarité (histoire, arts et français).
CELEBRATION DU DEBUT D'ANNEE AVEC LA BENEDICTION DES CARTABLES
Jeudi 1er octobre 2020, nous avons pu célébrer la rentrée avec la bénédiction des cartables. Tous les enfants étaient réunis afin de participer à ce premier « temps fort » de notre établissement. Enfin, tous ensemble, nous avons profité de ce moment pour entamer cette nouvelle année. Le thème de l’année a été de nouveau énoncé aux écoliers :
« Je peux faire des choses que vous ne pouvez pas, vous pouvez faire des choses que je ne peux pas; Ensemble, nous pouvons faire de grandes choses. » MERE TERESA


Lundi 14 septembre 2020, le conseil général nous a fait parvenir des calculatrices et un livre pour tous les élèves de 6ème. Monsieur Leroux, Maire de la commune, est venu en faire la distribution. De plus, grâce au conseil général, tous les élèves du collège Saint Georges ont reçu 5 masques en tissus en début d’année scolaire.


JOURNEE D’INTEGRATION DES 6EME
Mardi 1 septembre 2020, tous les élèves de 6ème ont pu se rencontrer, se découvrir ou se retrouver lors de cette journée de rentrée un peu spéciale pour eux. Madame Colnot, professeur principal d’une classe, a pu travailler à ce projet dès le mois de juin afin de préparer aux enfants, une journée parfaite. Ils ont pu par petits groupes, accompagnés d’enseignants, sillonner notre ville et apprendre, jouer, développer de nouvelles amitiés autour d’un pique-nique. Le Père Christophe a également accueillis les élèves dans l’église et a fait sonner Régulus, niché dans le clocher (représentant un général romain symbole de la parole donnée. Le temps fût clément, voire beau. Bref, ce fût une belle journée!





Chers parents,
Nous voici à la rentrée 2020. Malgré la COVID circulant toujours, notre établissement, comme tant d’autres, s’organise afin d’apporter à tous les enfants et les adultes, une sécurité maximum.
A chaque protocole, nous réadaptons notre organisation afin de respecter les règles sanitaires.
Soyez assurés que nous faisons tout ce qui est en notre pouvoir pour la protection de tous. Rassurez-vous, rassurez vos enfants. Chacun doit néanmoins respecter tout ce qui est mis en place dans l’établissement afin de maintenir la sécurité pour tous. C’est essentiel !
Je vous souhaite une belle rentrée et sachez que les deux cheffes d’établissement seront ravies de vous revoir !
Prenez soin de vous et de vos proches.
A bientôt.
Christine THABOURIN

CORONAVIRUS
Pour suivre l’actualité concernant le Coronavirus, voici le lien vers le site du Ministère de l’Education et de la Jeunesse : https://www.education.gouv.fr/coronavirus-covid-19-informations-et-recommandations-pour-les-etablissements-scolaires-et-les-27425
Gestes barrières :
- Lavage des mains fréquemment avec de l’eau savonneuse ou hydro alcoolique,
- Distanciation,
- Pas de serrage de mains et d’embrassades,
- Eternuements dans le coude,
- Masque obligatoire sauf pour les enfants de maternelle et de primaire
- Utilisation de mouchoirs à usage unique.

REMISE DES TABLEAUX D’HONNEUR AUX ELEVES DE 3ème EN JUIN 2020




NOS PORTES OUVERTES DU SAMEDI 1er FEVRIER 2020









SEMAINE DE LA PERSEVERANCE SCOLAIRE DU 5 AU 12 FEVRIER 2020 AU COLLEGE SAINT GEORGES
Notre collège a participé a cette semaine de la persévérance scolaire en mettant en scène la problématique des émotions avec des classes de 5ème. Merci aux enseignants qui ont contribué à ce travail, notamment Mme Boulier, professeur de français.

JOURNEE ORIENTATION POUR LES ELEVES DE 4ème
Vendredi 7 février 2020, tous les élèves de 4ème se sont rendus au 1er salon de l’orientation à Rouen. Ils ont pu rencontrer de nombreux professionnels et découvrir des secteurs d’activités dont ils n’avaient pas connaissance. Il est important que les élèves commencent à réfléchir à leur orientation dès la 4ème afin de pouvoir préparer ou affiner leur projet professionnel. Une journée réussie qui sera à renouveler l’an prochain.

Mardi 21 janvier, tous les élèves de 3e ont pu faire la connaissance d’André Biaux, résistant déporté, commandeur de la légion d’honneur.
Plus qu’une simple rencontre, André Biaux est porteur de mémoire. Une mémoire vivante qui s’est transmise au cours de son témoignage auprès des élèves. Ces derniers ont alors découvert son entrée progressive en résistance et ses motivations en 1940, son arrestation et sa déportation en 1944 et sa longue libération. André Biaux, dans toute sa gentillesse et sa simplicité, a ensuite ouvert un dialogue avec les élèves, riche en anecdotes et en intimité.
Les élèves ont beaucoup apprécié cette rencontre qui nous servira de levier dans la création d’un film présenté au concours national de la Résistance et de la déportation.
Nous le remercions infiniment pour son témoignage.
Si vous voulez en savoir plus sur André Biaux, vous pouvez consulter ce lien :
https://www.paris-normandie.fr/mobile/actualites/societe/andre-biaux-ebroicien-resistant-deporte-en-allemagne-a-ete-fait-commandeur-de-la-legion-d-honneur-IB16247960
NOEL 2019 A SAINT GEORGES : PREPARATION ET FESTIVITES

LE MARCHE DE NOEL INTERIEUR

TELETHON LE 6 DECEMBRE 2019
Tout l’établissement s’est mobilisé en courant pour cette journée TELETHON. Chaque tour apportait de l’argent pour aider la recherche contre la myopathie. Les directrices ont couru également pour l’association dont ses membres sont venus nous rencontrer.

PROJET PROVENCE SUR LE NIVEAU 5ème
Découverte des Gladiateurs et du voyage en Provence. A travers le biais d’affiches sur les thèmes abordés pendant le voyage : Gladiateurs, les arènes…. Ainsi qu’une exposition photos, nous pourrons recréer l’ambiance de notre voyage pour en faire profiter nos visiteurs.
Le début des travaux pour la maquette. Et dessin du 1er gladiateur Marmillion qui va nous accompagner une partie de l’aventure.



DECOUVERTE DE L’ABOUTISSEMENT DES TRAVAUX LORS DES PORTES OUVERTES LE SAMEDI 1er FEVRIER 2020 de 9h à 12h…
PROJET CREATION D’UN TRIVIAL PURSUIT SUR LE NIVEAU 6ème
Principalement sur le niveau 6ème, mais les 5ème pourront s’y intégrer également. La création d’un trivial pursuit. Nous allons créer avec les élèves notre propre jeu. Sur la base du jeu réel, nous allons fabriquer le plateau, les camemberts, suivant nos exigences. Les questions aborderont principalement les deux thèmes de l’année : « l’Amour rend tout aisé » et « l’Ecosystème ». Nous ajouterons également quelques thèmes choisis par les élèves. Ce projet une fois le jeu terminé, les élèves pourront prendre plaisir à y jouer.


Mardi 10 décembre 2019, des membres du conseil départemental sont venus distribuer aux élèves de 6ème, des bandes dessinées sur Gisacum. Monsieur Le Roux, Maire de Beaumont le Roger était présent et participait à la distribution.


Copyright Etablissement Saint Georges – Tous droits réservés
VENDREDI 22 NOVEMBRE 2019 : REMISE DES DIPLOMES DU DNB EN PRESENCE DE MONSIEUR LE ROUX, MAIRE DE BEAUMONT LE ROGER
Nos anciens élèves ont été accueillis par le nouveau chef d’établissement à 19 heures vendredi. Pointait un peu de nostalgie. Ils étaient heureux de se retrouver, de revoir certains de leurs enseignants. Les parents avaient le sourire. La céremonie de remise des diplômes du DNB a été suivie d’un moment festif autour d’un verre.


Vous devez être connecté pour poster un commentaire.